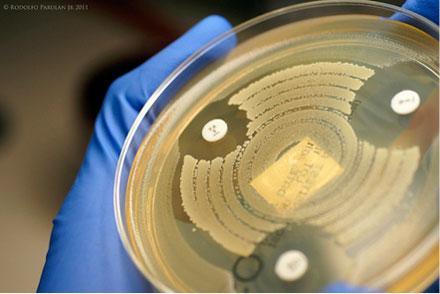

Abstract
Introduction: Development of antimicrobial resistance is an ongoing and increasing problem. To provide the best possible treatment for patients it is crucial that clinicians are aware of the local antimicrobial susceptibility patterns. The aim of this study was to present an overview of the percentage of bacterial isolates that are covered by the most commonly used antibiotics in the area of Copenhagen and to provide clinicians with a practical tool to help chose the right antimicrobial treatment for their patients.
Methods: We conducted a study of all bacteria isolates tested for antimicrobial susceptibility at Hvidovre Hospital, Denmark, from 2004 to 2008. Due to a suspected rise in resistance in Staphylococcus aureus, Escherichia coli and Klebsiella pneumoniae after this period, updated data for these bacteria are shown for selected antibiotics until 2014. The department receives samples from hospitals as well as from primary health care. Only one isolate per species per patient per year was included.
Results: A total of 224,033 bacteria isolates were included in this study. The antimicrobial susceptibility of the various bacteria is presented in a table. No clinically relevant changes in resistance patterns were noted up to 2014.
Conclusion: A comprehensive and manageable inventory of the resistance patterns of the major bacteria covering the 2004-2008 period is presented. Clinicians are encouraged to use the pocket-size table as guidance when choosing antibiotic treatment.
Funding: none.
Trial registration: not relevant.
Abstract
Introduction: Development of antimicrobial resistance is an ongoing and increasing problem. To provide the best possible treatment for patients it is crucial that clinicians are aware of the local antimicrobial susceptibility patterns. The aim of this study was to present an overview of the percentage of bacterial isolates that are covered by the most commonly used antibiotics in the area of Copenhagen and to provide clinicians with a practical tool to help chose the right antimicrobial treatment for their patients.
Methods: We conducted a study of all bacteria isolates tested for antimicrobial susceptibility at Hvidovre Hospital, Denmark, from 2004 to 2008. Due to a suspected rise in resistance in Staphylococcus aureus, Escherichia coli and Klebsiella pneumoniae after this period, updated data for these bacteria are shown for selected antibiotics until 2014. The department receives samples from hospitals as well as from primary health care. Only one isolate per species per patient per year was included.
Results: A total of 224,033 bacteria isolates were included in this study. The antimicrobial susceptibility of the various bacteria is presented in a table. No clinically relevant changes in resistance patterns were noted up to 2014.
Conclusion: A comprehensive and manageable inventory of the resistance patterns of the major bacteria covering the 2004-2008 period is presented. Clinicians are encouraged to use the pocket-size table as guidance when choosing antibiotic treatment.
Funding: none.
Trial registration: not relevant.
The increase of antimicrobial resistance challenges the clinician who is selecting empiric antibiotic treatment for patients. Certain bacteria appear persistently resistant to a number of antibiotics or even acquire resistance to several antibiotics over time and during the treatment course [1-4]. Infections involving resistant bacteria are associated with an increased morbidity and mortality as seen for fluoroquinolone-resistant Salmonella species [5], methicillin-resistant Staphylococcus aureus (MRSA) [6] and penicillin-resistant Streptococcus pneumoniae (pneumococci) [7]. As the identification of the aetiological pathogen is usually determined later than the need for treatment, knowledge of the local antimicrobial susceptibility patterns is fundamental to provide the correct initial treatment.
The efficacy of antimicrobial treatment depends on the minimum inhibition concentration (MIC) as well as the antibiotic concentration at the focus of infection over a period of time [8]. The susceptibility profile, covering a range of antibiotics, is called the bacteria’s antibiogram. General recommendations on symptomatic treatment of infections are frequently a topic of discussion. Usually, local recommendations and local guidelines exist alongside the national guidelines which are updated annually online in Denmark [9].
The aim of our study was to provide an overview of bacterial strains identified in a five-year period at the Department of Clinical Microbiology at Hvidovre Hospital, Denmark, and to present their antibiograms in order to provide clinicians with a helpful tool that can assist and help them in selecting the proper antibiotic treatment. The study also aimed to describe the development of antimicrobial resistance for S. aureus, Escherichia coli and Klebsiella pneumoniae in the subsequent period. We compared our findings with national surveillance data from Statens Serum Institut (SSI), the National Food Institute and the Danish Veterinary and Food Administration, which publish an annual report on antimicrobial susceptibility patterns in Denmark for certain bacteria from humans, animals, and food, DANMAP [10].
METHODS
Design and settings
We conducted a study based on antibiograms from all bacterial strains tested for antimicrobial susceptibility at the Department of Clinical Microbiology at Hvidovre Hospital in the five-year period from 2004 to 2008. Only one isolate per species per patient per year was included. Additionally, data on susceptibility profiles for S. aureus, E. coli and K. pneumoniae in the 2008-2014 period were obtained.
The department analysed patient samples from hospitals and primary health care (e.g. 38% hospital and 62% primary care samples in 2008). Samples from the hospitals of Amager, Bispebjerg, Bornholm, Frederiksberg, Hvidovre and also samples from primary health care in the municipalities of Frederiksberg and Copenhagen were all analysed at the department. As from 2011, samples from Glostrup Hospital and ten municipalities in the Greater Copenhagen area were also analysed at the department.
Data collection and determination of susceptibility
Bacterial strains isolated from all types of specimens were included, e.g. E. coli in urinary tract infections, and pneumococci commonly found in the respiratory organ. Strains were identified using traditional clinical microbiological methods [11], and susceptibility testing was performed according to the EUCAST methodology [12]. The registered antibiograms for the five-year period were pooled according to clinical relevance, e.g. S. aureus separately but all coagulase-negative staphylococci together. In case of resistance towards several antibiotics with the same mechanism of action, class-resistance and the susceptibility towards a single antibiotic were extrapolated to other antibiotics as presented in Table 1.
When only sparse data were available, i.e. less than 100 isolates or less than 50% of the isolates were tested, this was marked in Table 1. When both criteria defining sparse data were met, the data were excluded. All intermediate susceptible isolates were labelled as resistant in Table 1. Table 1 was completed based on literature [13] in those cases in which a certain combination of a bacterial species and antibiotic was not investigated in our data, but is, nevertheless, considered clinically relevant. In these cases, susceptibility was classified as “mostly resistant”, “variable” or “mostly susceptible”.
Trial registration: not relevant.
RESULTS
The antimicrobial susceptibility of 224,033 bacterial samples were tested during the 2004-2008 period and included in this study. The bacterial resistance patterns derived from the bacteria’s antibiograms are listed in
Table 1.
To establish the present-time usability of the table, antibiograms for S. aureus, K. pneumoniae and E. coli covering the 2008-2014 period were also included. The specific number of isolates, the tested antibiotics and the results are presented in Table 2. The susceptibility for S. aureus decreased significantly in the course of the 2008-2014 period, for both dicloxacillin and gentamicin, (p < 0.02 in both cases), although the susceptibility remained relatively high for both, above 97%. We found
a statistically significant decrease in cefuroxime susceptibility during over 2008-2014 period for E. coli (p = 0.018), but susceptibility was unchanged for gentamicin and ciprofloxacin in the same period. The susceptibility of K. pneumoniae to cefuroxime, gentamicin and ciprofloxacin increased in the 2008-2014 period, with p-values of < 0.001, 0.037, < 0.001, respectively.
DISCUSSION
This study presented a comprehensive overview of bacterial resistance patterns from a significant area of Copenhagen. Data were not segregated according to type or origin of infection, as bacterial resistance within the bacterial species is very similar across hospitals and general practices in our data which is in concordance with the national level surveillance for Denmark [10]. Although bacteria are found in a blood culture, they may originate from the patient’s gut, skin, airways or other foci. To ensure a complete and useful overview, samples from all five years were included as the level of resistance for most bacterial species in hospitals and primary health care has remained constant for the past ten years [10].
S. aureus, K. pneumoniae and E. coli are the main bacteria topreviously have shown alarming resistance development patterns [14, 15]. Therefore, data on these bacteria were updated.
MRSA have been of great interest in Denmark over the past decade due to an epidemic increase in Copenhagen ten years ago [16]. Our data showed a significant increase in MRSA from 1.8 to 3.0% during the 2008-2014 period (Table 2), which corresponds to the findings of DANMAP [10]. However, we found slightly more methicillin resistance than did DANMAP on a national scale. This discrepancy may be caused by a varying number of strains or a different distribution of specimen types. The observed changes in susceptibility since 2008 are of no clinical relevance. It therefore seems reasonable to state that, overall, the 2004-2008 data can still be used as a practical tool when choosing therapy in 2015. For S. aureus, both dicloxacillin and gentamicin, susceptibility remained relatively high, above 97%.
As demonstrated in Table 2, the resistance profiles of E. coli seem relatively stable, but a significant decrease in cefuroxime susceptibility from 96% to 93-94% was found. Our findings are in accordance with the 2013 DANMAP report. A notable finding in our study was the high susceptibility of E. coli to pivmecillinam (Table 1).
The development was more favourable for K. pneumoniae than for E. coli, as K. pneumoniae susceptibility to cefuroxime, gentamicin and ciprofloxacin increased significantly over the 2008-2014 period in the Copenhagen area (Table 2) and the susceptibility is now at the national level of resistance reported in DANMAP [10]. This decline in resistance can be explained by the effects of a large multidisciplinary intervention, including antimicrobial stewardship in one of the hospitals [17].
Another finding worth noticing was the penicillin susceptibility of pneumococci substantiating the present treatment recommendation for pneumonia in Denmark [9].
The present study benefits from a large number of samples from a geographical area including a comprehensive amount of data. Nevertheless, a number of limitations relating to the study need to be addressed. The subject is marked by constant development and change, and today’s relevance of data comprising samples obtained ten years ago (Table 1) may therefore be questionable. However, for the bacteria of greatest concern, data were obtained for 2008-2014. These data show that recent years’ changes in resistance do not interfere with today’s clinical guidelines (Table 2). Additionally, the present study is limited by solely including isolates from a particular area of Denmark. The clinician therefore has to be aware of possible local resistance patterns outside this region. Nevertheless, generally speaking,
according to DANMAP, no significant and consistent differences in the patterns of resistance exist across the country [10]. In order to enhance the clinical usability of Table 1, literature was used to complete the table where no or only scarce data were available in our database.
As often said about translational research, one could argue that this puts the table in a difficult position being both an inventory and a clinical tool. However, by
strictly reporting susceptible isolates from a large study material and combining these data with data obtained from the literature for rarer cases, this table does provide the clinician with a useful tool for clinical practice based on clinical research.
Other things than antimicrobial susceptibility need to be taken into consideration when treating patients, including side effects, risk of developing resistance, expenses, focus of infection, travel history, past and present treatment, nosocomial versus community-acquired infection, etc. Thus, we recommend that the clinician first and foremost consults local treatment instructions and national guidelines as they are published by the Danish Health and Medicines Authority [18] and by Danish Pharmaceutical Information online [9].
CONCLUSIONS
We have provided a comprehensive and practical table showing the resistance patterns in the area of Copenhagen from 2004 to 2008 for the most prevalent isolated pathogenic bacteria in man. Moreover, we presented the development in resistance patterns for S. aureus,
E. coli and K. pneumoniae from 2008 to 2014. These data can be used as guidance for the clinician who must choose between treatments for a given infection where the bacterial aetiology is suspected but culture results are not yet available. Regular data update in this field of research is desirable.
Correspondence: Julie Vestergaard Braüner. E-mail: julie_brauner@hotmail.com
Accepted: 7 July 2015
Conflicts of interest:Disclosure forms provided by the authors are available with the full text of this article at www.danmedj.dk

LITERATURE
1. Courvalin P. Antimicrobial drug resistance: “Prediction is very difficult,
especially about the future”. Emerg Infect Dis 2005;11:1503-6.
2. Gold HS, Moellering RC, Jr. Antimicrobial-drug resistance. N Engl J Med
1996;335:1445-53.
3. Skinhoj P. Den mikrobielle trussel. Ugeskr Læger 1998;160:6331-3.
4. Martinez JL, Baquero F. Mutation frequencies and antibiotic resistance.
Antimicrob Agents Chemother 2000;44:1771-7.
5. Helms M, Simonsen J, Molbak K. Quinolone resistance is associated with
increased risk of invasive illness or death during infection with Salmonella
serotype Typhimurium. J Infect Dis 2004;190:1652-4.
6. Gould IM. The clinical significance of methicillin-resistant Staphylococcus
aureus. J Hosp Infect 2005;61:277-82.
7. Tleyjeh IM, Tlaygeh HM, Hejal R et al. The impact of penicillin resistance
on short-term mortality in hospitalized adults with pneumococcal pneumonia:
a systematic review and meta-analysis. Clin Infect Dis 2006;42:788-
97.
8. Knudsen JD, Frimodt-Moller N. Correct dosage of antibiotics. The Danish
Society of Clinical Microbiology. Ugeskr Læger 2007;169:1115.
9. Dansk Lægemiddel Information A/S (DLI). Vejledning i brug af antibiotika.
http://pro.medicin.dk/Specielleemner/Emner/318019 2014 (20 Oct 2014).
10. Statens Serum Institut. Danmap. http://danmap.org/ 2014 (27 Oct 2014).
11. Murray PR, Baron EJ, Pfaller MA et al, eds. Manual of clinical microbiology.
8th ed. Washington DC: ASM Press, 2003.
12. Eucast. The European Committee on Antimicrobial Susceptibility Testing.
http://eucast.org/ 2013 April 6 (21 Oct 2014).
13. Lorian V. Antibiotics in laboratory medicine. 5th ed. Philadelphia:
Lippincott Williams and Wilkins, 2005.
14. Statens Serum Institut. EPI-NEWS, No. 11, 2008.
15. Statens Serum Institut. EPI-NEWS, No. 15, 2010.
16. Westh H, Boye K, Bartels MD et al. Epidemic increase in methicillinresistant
Staphylococcus aureus in Copenhagen. Ugeskr Læger 2006;
168:671-3.
17. Knudsen JD, Andersen SE, for the Bispebjerg Intervention group.
A multidisciplinary intervention against ESBL- and AmpC-producing gramnegative
bacteria at a University Hospital. PLoS One 2014;9:e86457.
18. Vejledning om ordination af antibiotika. Sundhedsstyrelsen 2012.
http://sundhedsstyrelsen.dk/publ/Publ2012/11nov/AntibiotikaOrdvejl.pdf
(27 Oct 2014).